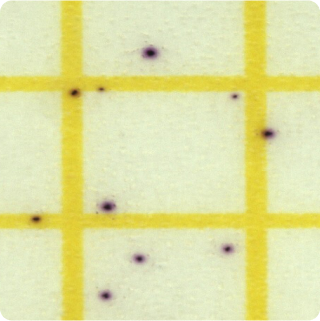

Staphylococcus aureus - Plate - 25g
SAUR
|
Turnaround Time:
2 - 4 days
|

Method Description
Staphylococcus aureus is a gram-positive bacterium that produces heat-stable enterotoxins causing rapid-onset food poisoning with symptoms including nausea, vomiting, and diarrhea. Testing is important for foods that require manual handling or are held at improper temperatures, as S. aureus commonly originates from human skin and nasal passages. The analysis helps identify contamination sources and validate food handling procedures.
Analyte List
Technical Data Sheet
Method Name
Enumeration of Staphylococcus aureus in Foods and Dietary Supplements
Method Code
LAB-TM-062
Equipment Type
Culture Media - Plate
Equipment Details
3M Petrifilm (STX)
Method Reference
USP <62> - Vendor Modified, USP <2022> - Vendor Modified, USP <1223>, AOAC OMA 2003.07
Reportable Unit
CFU/g, Swabs: CFU/Sw
Sample Size Requirements
100g
Available for
Food Products,
Dietary Substances,
Botanicals (Raw Materials, Extracts, Finished Products),
and Surface Swabs
Additional Information
Staphylococcus aureus is highly vulnerable to destruction by heat treatment and nearly all sanitizing agents. Therefore, the presence of this bacterium or its enterotoxins in processed foods or on food processing equipment is generally an indication of poor sanitation. (BAM Online Ch. 12 //www.cfsan.fda.gov/~ebam/bam-12.html)
Unavailable for
*Prices and offerings are subject to change without notice.